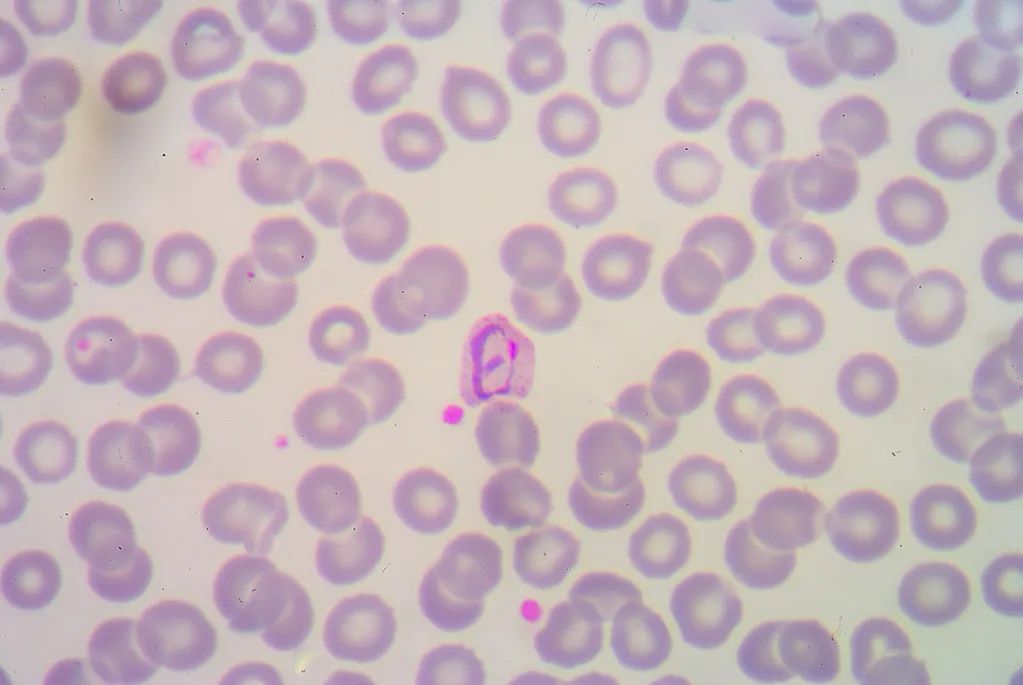
稳转株构建简介

相关产品推荐更多 >
万千商家帮你免费找货
0 人在求购买到急需产品
- 详细信息
- 技术资料
外源质粒DNA整合到宿主细胞染色体上,使宿主细胞可长期表达目的蛋白,称稳定细胞系。高质量的稳定细胞系在生物学研究中扮演着非常重要的角色,包括基因功能研究、重组抗体、药物开发等。
构建一个有效的细胞系是一件复杂而费时的工作。科沿有道拥有系列稳定细胞系构建专利技术及丰富的哺乳动物细胞培养经验,可以为您提供各种细胞系定制服务。我们已经众多客户构建了各种各样的定制细胞系,包括基因过表达(Reporter细胞系、GPCR细胞系、离子通道细胞系等)、Knockdown、Knockout细胞系等。
一、服务内容: 交付内容:高表达单克隆细胞株(1×10^7cells/ml,1ml)或 cell pool(1×10^7cells/ml,1ml);克隆载体;质检报告;实验流程报告。 二、周期: cell pool,8周;单克隆细胞株,12周。 三、稳定细胞系筛选流程:
1、载体构建:
三、稳定细胞系筛选流程:
1、载体构建:
目的基因过表达或沉默载体的构建。
2、病毒包装:表达载体、辅助质粒共转染293FT细胞,收集病毒上清,纯化和浓缩病毒颗粒。若选择转染,则跳过此步。
3、转染、转导:电转染或转染试剂(脂质体等)进行细胞转染,或病毒转导。
4、筛选:根据表达载体的筛选基因选择药物进行筛选,如嘌呤霉素、G418等。
5、扩大培养:将筛选出的单克隆细胞进行扩大培养。
6、鉴定:PCR、Q-PCR、western等从DNA、mRNA、蛋白水平进行检测。
风险提示:丁香通仅作为第三方平台,为商家信息发布提供平台空间。用户咨询产品时请注意保护个人信息及财产安全,合理判断,谨慎选购商品,商家和用户对交易行为负责。对于医疗器械类产品,请先查证核实企业经营资质和医疗器械产品注册证情况。
 技术资料
技术资料暂无技术资料 索取技术资料
稳转株构建
询价








![BaF3-fflu+TELKIT[D816E]稳转株](https://img1.dxycdn.com/p/s14/2025/0324/102/0270158097315004091.jpg!wh200)

